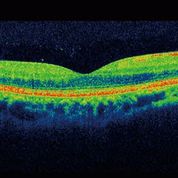
OCT

Call Us: 01691 654327
Our Services
Eye Tests
Your eyesight is a precious sense, so it is very important that you have regular eye examinations, at least every 2 years, whether you feel you need spectacles or not.
Contact Lenses
Whether you have been wearing contact lenses for years, or just fancy a change from wearing glasses we are here to help. Modern contact lenses are comfortable, easy to wear and suitable for most prescriptions.
Frames
Frame styles vary greatly, from the minimalist rimless to the bold and colourful, from the ultra modern to the vintage look. We have over 1,000 frames in stock from dozens of of different manufacturers.
Lenses
Being an independent opticians allows us to work with a range of lens manufacturers, including Hoya, Zeiss and Nikon, who are at the leading edge of modern lens design and technology.
Hummingbird Hearingcare
We have partnered with Hummingbird Hearingcare to offer our clients a range of hearing services combined with cutting-edge technologies including built-in artificial intelligence devices.
OCT
Ocular Coherence Tomography is a revolutionary piece of diagnostic equipment that can detect a number of common eye conditions and is available to clients of all ages.
Why Choose Us?
All of our services are designed to enable you to have the best possible vision in conjunction with your lifestyle needs.
-
What to expect
All of our services are designed to enable you to have the best possible vision in conjunction with your lifestyle needs. We aim to provide peace of mind with our screening and testing procedures. You're also able to choose from our extensive and carefully selected range of spectacle frames that will not only ensure you see well but look better too.
-
What to expect during your BBR eye Examination
The techniques and equipment that are employed by our Optometrist are nothing to be nervous about. An eye examination is not an unpleasant procedure and normally, will not last much longer than about 30 minutes.
-
Types of Contact Lenses we supply
Soft Contacts
By far and away the most common type of contact lens worn today. Great for sports activities, daily and also occasional wear, they provide wearers with tremendous freedom such as the ability to wear non-prescription sunglasses.
Daily Disposables
Since these lenses are designed to be worn once daily and then thrown away, they are great for busy individuals who do not have time for the normal soft lens regime of cleaning, disinfecting and storing. Also suitable for occasional wear.
Regular Replacement
Perhaps the most cost-effective lens type is the planned replacement lens. Often, this will be a two-week or monthly cycle where the lens is removed every day and stored overnight. These lenses are well suited for addressing astigmatism issues.Continuous Wear
Sometimes referred to as extended wear lenses, wearers can actually sleep in them and remove and replace them only once every 30 days. Specially constructed to permit enough oxygen to reach the eyes, they also require no storage regime.
Rigid Lenses
These lenses can take a little longer to get used to and initially are not as comfortable, but they have the advantage of not needing to be replaced as regularly as soft lenses. They are also suitable for a much larger range of prescription types.
Aftercare
Regular aftercare appointments are essential for maintaining the health and comfort of your eyes. At these, your optician will be able to give you reliable aftercare advice and can help if you have any problems with your lenses.
I would not go to any other optician in Oswestry. BBR are outstandingly professional. Eyes are incredibly valuable and mine are complicated and difficult to treat. Nothing has been too much trouble for BBR and they makes themselves available whenever needed. Pleasant, courteous and quietly reassuring staff.
Kathleen K
My wife and I have been regular patients at BBR for more years than we care to remember. It would never occur to us to go elsewhere. We have always enjoyed the friendly and efficient service. The actual eye examinations are so thorough and each visit seems to reveal another piece of futuristic equipment and patients' queries are answered in a way that even the old & confused can understand.
Eddie P
They constantly strive to improve the service they give and take pride in caring for their clients.
Judith B
They're wonderful. Having discovered this gem of an independent optician I wouldn't use anyone else now. I highly recommend them.
Phillip L